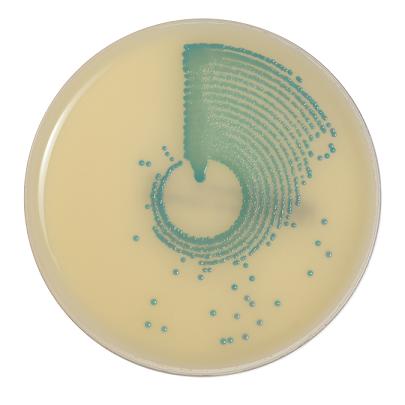

Channels
Special Offers & Promotions
bioM
bioMérieux has recently launched a new version of chromIDTM MRSA chromogenic medium for the detection of methicillin resistant Staphylococcus aureus (MRSA), providing a cost effective solution for rapid routine screening. A ready-to-use medium for the culture, isolation and identification of MRSA, it offers direct identification of MRSA strains within 18 hours, and sensitivity is increased by a further 7 % when flocked swabs are used for transportation providing a good synergy with the PREVI Isola automated plate streaker.
bioMérieux has recently launched a new version of chromIDTM MRSA chromogenic medium for the detection of methicillin resistant Staphylococcus aureus (MRSA), providing a cost effective solution for rapid routine screening. A ready-to-use medium for the culture, isolation and identification of MRSA, it offers direct identification of MRSA strains within 18 hours, and sensitivity is increased by a further 7 % when flocked swabs are used for transportation providing a good synergy with the PREVI Isola automated plate streaker.
The characteristic colours of the colonies - pale blue-green at 18 hours incubation and blue green to dark blue at 24 hours incubation - make results easy to read, and the medium has been validated for use with PREVITM Isola, VITEK®2 and API® platforms. With a maximum read time of 24 hours, compared to 48 hours for the previous version, the new version chromID agar has the potential to increase throughput significantly.
Daniel White, product manager, bioMérieux, said: "Compared to traditional culture media, chromogenic media offer the laboratory an easier method of identifying bacteria through colour differentiation. The intensity and specificity of the colours produced make rapid, easy identification of bacterial colonies possible; this new chromID MRSA chromogenic medium will be a great advantage to our customers releasing time and space within the laboratory while at the same time allowing earlier reporting of negatives to facilitate faster clinical decisions."
About bioMérieux
Advancing Diagnostics to Improve Public Health
A world leader in the field of in vitro diagnostics for over 45 years, bioMérieux is present in 150 countries through 39 subsidiaries and a large network of distributors. In 2008, revenues reached €1.111 billion with 84% of sales outside of France.
bioMérieux provides diagnostic solutions (reagents, instruments, software) that determine the source of disease and contamination to improve patient health and ensure consumer safety. Its products are used for diagnosing infectious diseases and providing high medical value results for cancer screening and monitoring and cardiovascular emergencies. They are also used for detecting microorganisms in agri-food, pharmaceutical and cosmetic products. bioMérieux is listed on the NYSE Euronext Paris market (Code: BIM - Code ISIN: FR0010096479). Other information can be found at www.biomerieux.com.
Media Partners


